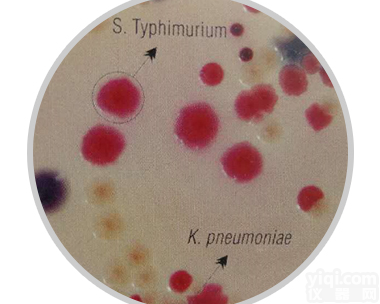
改良沙门氏菌<em>RajHans</em>显色培养基
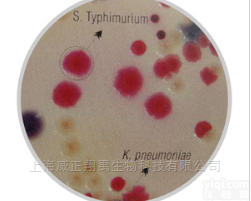
M1633  改良沙门氏菌<em>RajHans</em>显色培养基

Salmonella Agar, Modified (HiCrome RajHans Medium, Modified)
- 品牌:Himedia
- 型号:M1634
- 产地:India
- 供应商:西宝生物科技(上海)股份有限公司
- 供应商报价:询价
- 标签:Salmonella Agar, Modified (HiCrome RajHans Medium, Modified)、Salmonella Agar, Modified (HiCrome RajHans Medium, Modified)价格、Salmonella Agar, Modified (HiCrome RajHans Medium, Modified)厂家、Salmonella Agar, Modified (HiCrome RajHans Medium, Modified)、、西宝生物科技(上海)股份有限公司
信息声明:本产品供应信息由仪器网为您整合,供应商为(西宝生物科技(上海)股份有限公司),内容包括
(Salmonella Agar, Modified (HiCrome RajHans Medium, Modified))的品牌、型号、技术参数、详细介绍等;如果您想了解更多关于
(Salmonella Agar, Modified (HiCrome RajHans Medium, Modified))的信息,请直接联系供应商,给供应商留言!